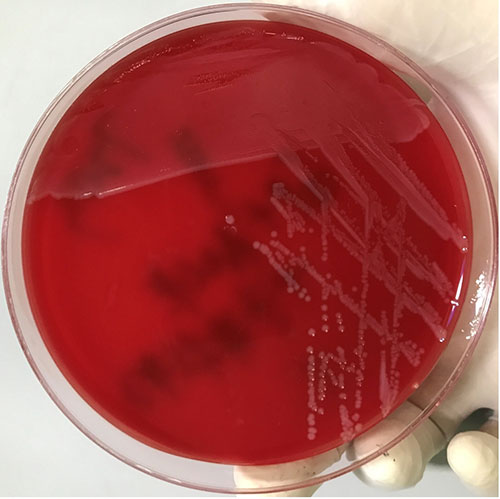
kp1.jpg

关注我们


“冰箱杀手”—产单核细胞李斯特菌(简称LM,图1),广泛存在于自然界中,可以耐低温生长,是一种人畜共患致病菌,产单核细胞李斯特菌通常存在于动物来源经加工或未加工的食物中,尤其是软奶酪、熟食肉类、热狗、牛奶和凉拌沙拉。单核李斯特菌主要通过食用被污染的食物而发生感染(90%),孕妇感染后可以通过胎盘或产道感染胎儿或新生儿,引发流产或死胎。单核李斯特菌感染潜伏期为3-70天,平均潜伏期为3周。多数病例为散发,但也有暴发流行。1981年加拿大发生了因食用被污染的卷心菜爆发了李斯特菌病疫情;1999年,美国也发生了因食用单核李斯特菌污染的“热狗”和熟肉而引发的97人感染14人死亡,6名孕妇流产的历史上最严重的食物中毒事件。我国也发生过类似的单核李斯特菌感染事件,自2000年起我国开展了食品单核李斯特菌监测,绝大多数食品中都能找到单核李斯特菌,其中污染率较高的食品主要为生肉及肉制品,污染率约30%,其中生鸡肉、生猪肉分列前两位,此外乳制品、水果、沙拉、海产品、冰淇淋等也具有较高的污染率。
图1 单核李斯特菌培养性状
产单核李斯特菌感染,可表现为胃肠炎、菌血症、脑膜炎、局灶性中枢神经系统感染,其中以脑膜炎和菌血症最为常见。如果能及时诊断和治疗,多数患者能完全康复,因此,成功治疗单核李斯特菌感染的关键是及时获得实验室病原学诊断。
广东省人民医院临床微生物室将工作流程与“一步法”划时代全自动血培养系统、MALDI-TOF MS质谱仪充分融合,我们成功的将血培养产单核李斯特菌的实验室诊断从80小时缩短至14小时(图2),为快速确诊病原体提供了强有力的支持。

图2 血培养单核李斯特菌实验室诊断流程
刘素玲,张妮